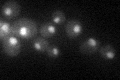
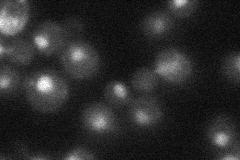
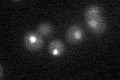

View description
Subunit of the SAGA transcriptional regulatory complex, involved in proper assembly of the complex; also present as a C-terminally truncated form in the SLIK/SALSA transcriptional regulatory complex
Localization:
Intensity:
Fold change:
Significance:
-
C’ GFP library in SD
nucleus29.16 -
N' NOP1pr-GFP in SD

nucleus47.3245 -
N' TEF2pr-mCherry in SD

nucleus68.9064 -
N' NATIVEpr-GFP in SD
nucleus30.7462 -
N' TEF2pr-VC and Cyto-VN in SD

nucleus24.9753 -
C’ GFP library in SD+DTT

nucleus24.390.83No -
C’ GFP library in SD+H2O2

nucleus32.491.11No -
C’ GFP library in Starvation Media
nucleus25.820.88No -
C’ GFP library on the background of Pup2-DaMP

nucleus -
C’ GFP library on the background of CCT mutant

nucleus31.6251.08427No
